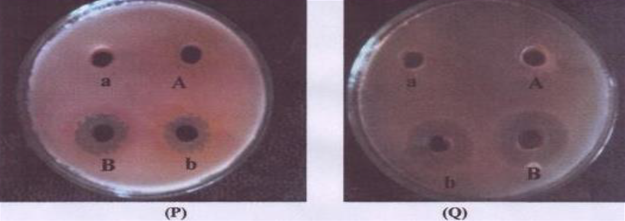

SNAP Industries and Alginates Limited
(Plot No. 1, Sipcot Industrial Estate, Ranipet, Tamil Nadu) A full-scale plant of capacity 40KLDwith high TDS and Zero Liquid Discharge.
-
Inlet effluent:
- pH: 1.5 – 1.6
- TDS – 35000 ppm (Average)
- Flow – 40 KLD
- TDS Load: 1400kg/day
-
Problem:
Huge amount of sludge generation due to evaporation of 40KLD high TDS effluent in natural evaporation ponds
-
Objective:
- Reduction of chemical cost for neutralization and evaporation
- Maintain zero liquid discharge and TDS sludge
-
Treatment given:
- Phycoremediation by using the wastewater for growing microalgae.
-
Post-treatment:
- pH: 7.5-8.0
- Daily sludge generation – 500kg
-
Key points:
- The Company has developed 2 value added products from the harvested algal biomass and the products are sold at Shrimp Farms in Andhra Pradesh as a shrimp feed and at Tea Gardens as fertilizersupplement.
- The company is earning substantial amount from selling theproducts developed from the algal biomass which is generated from thetreatment of the effluent.
- This is one of the first Phyco-Remediation plant for Industrial EffluentTreatment and also a Profit Making ETP.



Pasupati Acrylon Ltd.
(Kashipur Road, Thakurdwara, Uttar Pradesh) Full Scale 72 KLD, Treatment & Discharge Plant
-
Inlet Effluent Detail:
- pH: 2-3
- TDS: <500 ppm
- COD: 600 ppm – 1800 ppm
- Flow: 3 M3/hour – 4 M3/hour
- Colour: 1000 -2000 Co-Pt
- Microbial Toxicity: Very high
-
Problem:
High microbial toxicity of generated effluent disturbed the normal functioning of ETP to an extent that the industry stopped the gel dyed fabric manufacturing till a solution was achieved.
-
Objective:
- To remove microbial toxicity of effluent so that it can be treated in ASP.
- ii. To reduce the color, COD of effluent and neutralize the pH without chemicals.
-
Treatment given:
- Phycoremediation, treatment of gel dyeing effluent using microalgae.
-
Post-treatment:
- Microbial toxicity of the raw effluent was completely removed and the effluent was taken for ASP (7800m3).
- Post Phycoremediation, the effluent showed no phytotoxicity.
- Color, pH, COD and BOD problems wereeffectively resolved.




Brinton’s Carpet Ltd
Village - Urwade, Pirangut, Maharashtra - 412108 0.5 KLD Zero Liquid discharge Plant – Pilot Plant
-
Inlet Effluent Detail:
- pH: 6 – 8.5
- TDS: App 20,000 ppm
-
Problem:
Treatment of high TDS RO reject water generated after treatment of dye effluent from ETP
-
Objective of Treatment Plant:
- To maintain the pH at neutral
- To evaporate the water and achieve Zero Liquid Discharge Plant
- To reduce the TDS sludge generated due to evaporation
-
Treatment given:
- Phycoremediation by using the high TDS RO reject water for growing microalgae
-
Post-treatment:
- 70-80% TDS removal was achieved based on actual TDS load entering and accumulating into tank as algal biomass.


Hettich India Pvt Limited
Village – Dhanora, Near VECL, Near Nandesari GIDC Opp. Reliance Industries Ltd, Vadodara, Gujarat [2.5 KLD Zero Liquid Discharge Plant]
-
Inlet Effluent Detail:
- pH: 0.5 to 5.9
- TDS: 25000-30000 ppm
- Heavy metals: 10-1500 ppm
-
Problem:
2.5 to 3 KLD effluent with very high TDS and acidic pHwhich can’t be treated with multi effect evaporator due to high costs.
-
Objective of Treatment Plant:
- To neutralize the effluent without addition of any chemicals.
- To reduce the TDS load and heavy metals in the reaction tank.
-
Treatment given:
- A 300 litres per day pilot plant was initially set-up which was scaled to fully functional 2.5 KLD plant for processing of the effluent via micro-algal technology
-
Post-treatment:
- The pH was neutralized in the range of 8 – 8.5, 77% of TDS was removed, along with heavy metals as observed from algal biomass analysis.


Gujarat Agrochem Ltd
Panoli GIDC, Panoli, Ankleshwar, Gujarat 10 KLD Zero Liquid Discharge Pilot Plant
-
Inlet Effluent Detail:
- pH: 4.5 to 13.5
- TDS: ~70,000 ppm
- COD: ~25,000 ppm
- NH3 - N – 50-300 ppm
-
Problem:
High treatment costs of effluent with high TDS and COD using MEE.
-
Objective of Treatment Plant:
- To neutralize the pH of effluent without any chemical addition.
- To evaporate the effluent and achieve Zero Liquid discharge system.
- To reduce the TDS sludge from the system.
-
Treatment given:
- A pilot plant of 0.5 KLD was set-up which was further scaled-up to 10 KLD for processing of the effluent via micro-algal technology
-
Post-treatment:
- The pH was neutralized in the range of 8 – 8.5, 77% of TDS was removed, along with heavy metals as observed from algal biomass analysis.



K.H. Exports India Pvt Ltd
Ranipet, Tamilnadu [1 KLD Zero Liquid Discharge Pilot plant]
-
Inlet Effluent Detail:
- pH: Neutral
- TDS: ~25,000 ppm
-
Problem:
High TDS effluent of the RO reject which is evaporated very slowly in solar evaporation tanks generating high amount of sludge.
-
Objective of Treatment Plant:
- To reduce the TDS of the RO reject effluent.
-
Treatment given:
- A pilot plant of 1 KLD was set-up which was used for processing of the effluent via micro-algal technology
-
Post-treatment:
- The total TDS was reduced by 32% as observed from algal biomass analysis. Total chlorides were also reduced by approximately 41%.

Yuti Textiles Process Pvt Ltd
Village Dyane, Malegaon 1 Kld Treatment And Discharge Pilot Plant
-
Inlet Effluent Detail:
- pH: 12-13
- TDS: ~5,000 ppm
- COD: ~3200 ppm
- BOD: ~1100 ppm
-
Problem:
Reducing pH to neutral range was costly to the company and the Activated Sludge process was not functioning properly due to high PVA used in the process.
-
Objective of Treatment Plant:
- To reduce the COD by 80-85 % and to take the same for clarification and RO system.
- To neutralize the pH of effluent without any chemical addition.
- To reduce the content of PVA from the effluent to take the effluent in the RO system.
-
Treatment given:
- A pilot plant of 1 KLD was set-up which was used for processing of the effluent via micro-algal technology
-
Post-treatment:
- The pH in the Algae Tank was found constantly between 8 to 8.5.
- The COD of the outlet water after sludge settling and sand filtration was in the range of 300 - 400 ppm. BOD was reduced by more than 90%.



Ramky Enviro Engineers Ltd
(Reel), Msw Disposal Hyderabad [0.5 Kld Zero Liquid Discharge Pilot Plant]
-
Inlet Effluent Detail:
- pH: 4.5-8.5
- COD: 24000 - 41000 ppm
- TDS: 4700 - 46000 ppm
-
Problem:
MSW treatment generates huge quantities of solid waste leachate which is complex to treat with high TDS and COD values. Solar evaporation of the leachate water generated high quantities of TDS sludge
-
Objective of Treatment Plant:
- To neutralize pH without addition of any chemical.
- To reduce the TDS sludge generation.
- To evaporate the effluent and provide the Zero Liquid Treatment solution.
-
Treatment given:
- A pilot plant of 0.5 KLD was set-up which was run for 2 months to provide zero liquid discharge.
-
Post-treatment:
- The pH of the MSW leachate was raised from 4.5 to 8 in 24 hours in algae reaction tank.
- The TDS and COD load was removed by approximately 70% by the applied micro-algae technology

Tata Steel
Jamshedpur – Bihar
-
Problem:
High concentrations of Cyanides, ammonia, and other organic contamination in the wastewater generated from coke oven
-
Objective of Treatment Plant:
- To remove, ammonia, cyanide and color from the generated wastewater.
- To reduce annual hypochlorite consumption.
-
Treatment given:
- Microalgal treatment was conducted for the effluent treatment.
-
Post-treatment:
- 65% and 95% reduction in cyanide and Ammonia was obtained.
- Significant reduction in color was obtained post-treatment.